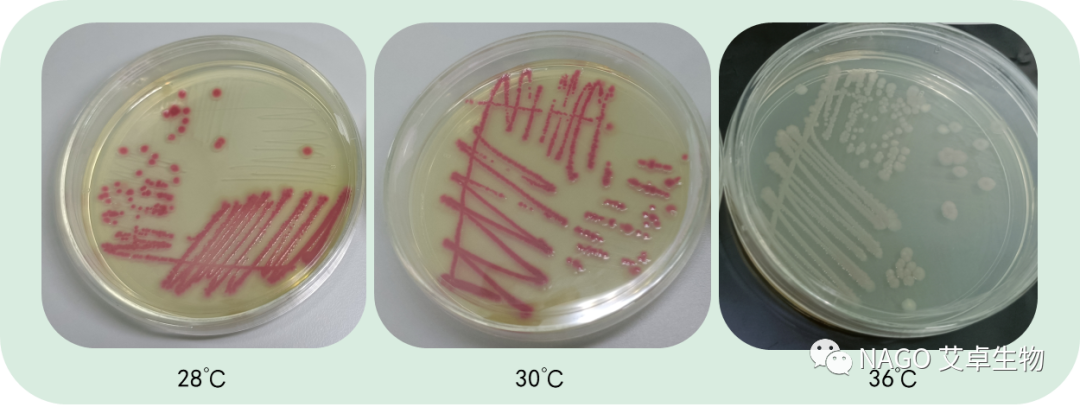

??

最近小編在走訪市場客戶時,收集到一個比較有意思的信息,有消費者在使用洗面奶時發現瓶口有“泛紅”的情況。網上對這個現象有研究的也比較少,僅有一兩個帖子有相關的討論。隨后小編也將“瓶口變紅”的樣品帶到了實驗室進行研究。下文將對這個情況進行詳細的剖析。

針對“瓶口泛紅”現象,網帖上的結論:產品中某些成分被氧化導致產品變色。
據小編所知是有很多物質被氧化之后會出現顏色變化,比如苯酚,苯酚暴露在空氣中少量被空氣氧化為對苯醌,再與苯酚結合生成一種復雜的紅色物質使苯酚顯粉紅色,久露空氣中可變為深紅色。當然,苯酚是禁用物質,所以不應該會出現在產品中。除苯酚外,具有酚羥基結構的物質都有可能出現類似的變色現象。

除了物質被氧化這個原因之外,我們分析洗面奶長期放置在潮濕的環境,加上瓶口位置也經常需要開合取用,有可能存在微生物問題。為了驗證猜想,我們送樣到實驗室進行了檢測。
檢測結果為:紅色物質是沙雷氏菌產生的次級代謝物-靈菌紅素。
我們生活中常見的是沙雷氏菌是粘質沙雷氏菌(Serratia marcescens),又稱靈桿菌,廣泛分布于自然界,是水和土壤中的常居菌群,為細菌中最小者,約0.5×(0.5~1.0)微米。 近年來發現其可致人體感染,在人體免疫功能受損時可導致呼吸系統感染、泌尿系統感染等情況發生,其已經成為臨床上常見的條件致病菌,危害人體健康。
而這次我們實驗室發現的這種沙雷氏菌的次級代謝物靈菌紅素,它的產生是需要一定條件的,比如溫度。下圖是沙雷氏菌在不同溫度下培養的菌落顏色對比。
從結果來看,28℃與30℃下培養的沙雷氏菌顏色差別不大,都呈現紅色;36℃下培養的則呈現淡粉色;高于36℃基本上就不再產生靈菌紅素。
據研究表明:靈菌紅素這種代謝產物本身不是有害物質!但我們從技術研究的角度認為,沙雷氏菌也有可能產生其他的代謝產物,難以保證其他種類的代謝產物不會帶來刺激、過敏等各種皮膚問題。
那很多網友就會問,像這種瓶口“泛紅” 、“變粉”的洗面奶我們還能繼續使用嗎?為什么產品會在我們日常使用過程中會受到污染呢?
綜上所述,無論是微生物的原因,還是產品本身穩定性欠佳,對于使用者來說都可能存在隱患。
從安全性的角度考慮,我們還是建議大家:停止使用。
關于產品受到污染的原因,我們認為可能性可以有很多種,主要有以下兩點:
① 產品本身防腐體系偏弱,產品長時間暴露在不良環境中,導致產品被污染;
② 消費者在使用過程中,一些不恰當的使用或存放方式改變了產品的狀態和性質,導致產品被污染。

文章的最后,小編提醒大家需要辯證地來看待我們生活中存在的微生物。微生物無處不在,大家也不用恐慌。同時,化妝品中富含大量的營養物質,是微生物繁殖的溫床,適當地添加一些具有抑菌性能的防腐劑在化妝品中還是很有必要的。


關閉